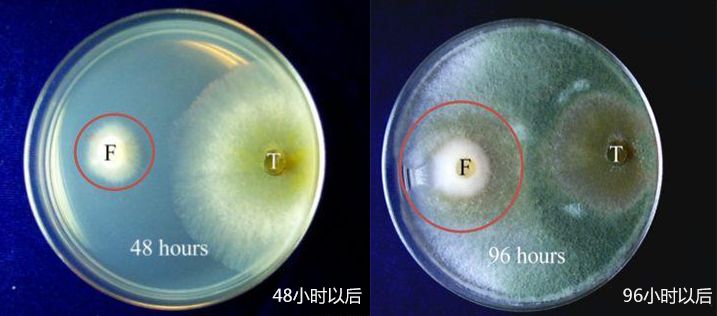

一、關于哈茨木霉菌
木霉菌是自然界廣泛分布的真菌,是土壤微生物的重要群落,自1932年,Windling 初次發現木霉菌對植物病原真菌有拮抗作用,木霉菌便開始受到關注,后被廣泛運用于農業生產之中。
![]() 顯微鏡下的木霉菌
顯微鏡下的木霉菌
木霉菌屬于半知菌類的絲孢綱叢梗孢目叢梗孢科,地球上已知的大概有80多種木霉菌,能夠快速產生孢子,可以市場化的主要有哈茨木霉、深綠木霉、長枝木霉菌、短密木霉等。
二、哈茨木霉菌防治生姜土傳病害的原理
哈茨木霉菌通過快速生長把生姜根際周圍的空間占住,使病原菌的生存空間減少,從而使減少了病原菌侵染根系的機會。
木霉菌遇到生姜根系周圍病菌時,還會分泌抗生素及細胞壁水解酶破壞病菌的菌絲,使病菌菌絲無法正常生長,從而抑制病原菌生長的作用(拮抗作用)。
哈茨木霉菌實驗
F:鐮刀菌 T:哈茨木霉菌
紅色圓圈內為鐮刀菌菌落
培養96小時:哈茨木霉菌的菌落要遠遠大于鐮刀菌的菌落。
顯微鏡下觀察研究發現:
①鐮刀菌菌絲被哈茨木霉菌所分泌的抗生素、細胞壁水解酶困鎖住。
②哈茨木霉菌菌絲也開始在鐮刀菌菌絲上寄生生長。
③鐮刀菌逐漸被哈茨木霉菌“吞沒”。
三、哈茨木霉菌的功效:
1、在生姜根周寄存生長并形成保護膜,阻止生姜根部有害菌的侵染,疏松通氣改良土壤的微環境,根壯苗旺減少有害菌傳播。
2、 阻斷病原菌繁殖生長所需養分,破壞細胞膜來抑制孢子萌發管的生長;使有害菌孢子枯竭脫養,防治真菌細菌擴繁;清理作物有害菌源的侵染,讓受損根系快速恢復生長。
3、哈茨木霉菌分泌的生物酶及活性物質刺激生姜末端細胞生長發育,促使根系生長,弱苗復壯,病株復康。